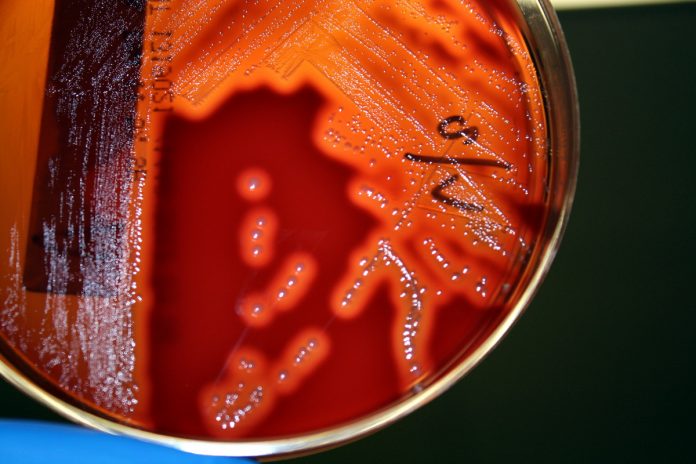
cultivo-streptococcus-pyogenes

Redacción Alta Gracia– La doctora Ana Do, Jefa de Pediatría del Hospital Arturo Illia, llevó tranquilidad a la población en cuanto a los efectos mortales que está causando la bacteria. «Estamos ante un alerta epidemiológico a nivel social, pero por ahora en Córdoba no hay casos».
Luego de que causara en los últimos días la muerte de dos niños en la ciudad de Buenos Aires y de otros dos en Misiones y Rosario, el estreptococo pyogenes sumó una víctima adulta de la ciudad de Perganimo (Buenos Aires).
Redacción Alta Gracia consultó sobre los alcances de esta bacteria y su prevención en la ciudad de Alta Gracia, sobre todo en el efector público más importante como el Hospital Arturo Illia.
Ana Do, Jefa del Departamento de Pediatría del Hospital Arturo Illlia, contó que «se han encendido las alarmas en distintas partes del país. Esta dolencia afecta a niños entre los 5 meses y 7 años. Tiene síntomas similares a los de la angina, aunque si invade la sangre puede tener una alta mortalidad ya que esta bacteria puede producir un shock infeccioso y neumonías con derrames de líquidos. La bacteria puede producir enfermedades más benignas como pueden ser infecciones en la piel o también puede producir una enfermedad que se conoce como escarlatina que da fiebre, dolor de garganta y una erupción cutánea (piel rugosa y caliente)».
Por otro lado, Do explicó que hay que estar atentos a los síntomas que pueden ser dolores fuerte de garganta, síntomas similares a los de la angina, fiebres con altísimas temperaturas. Si se detectan además lesiones en la piel, que pueden ser tipos granitos que luego se transforman en ampollas o costras, hay que consultar inmediatamente al profesional.
«El hisopado es un estudio que – en cuestión de horas- permite determinar si está presente esta bacteria. Para prevenir el contagio son los mismos pasos que seguimos para la gripe. Lavarse las manos con mucha frecuencia y mantenerla desinfectada (con alcohol en gel), higienizar si hay lesiones en la piel, que no tengan polvo. No hay que automedicarse. Si el médico indica antibiótico, hay que respetar el tiempo y los horarios de suministro del tratamiento», manifestó la profesional.
En relación a la situación que se está viviendo por estar horas en el nosocomio local, la pediatra Do dijo que «en el hospital no hemos tenido ningún caso, ni siquiera de angina por este germen, ni lesiones en piel. No hubo necesidad de tomar estas muestras (hisopado). Existe un alerta epidemiológica a nivel social ya que se produjeron casos de muertes en niños por esta bacteria. En Córdoba no tenemos casos», finalizó.